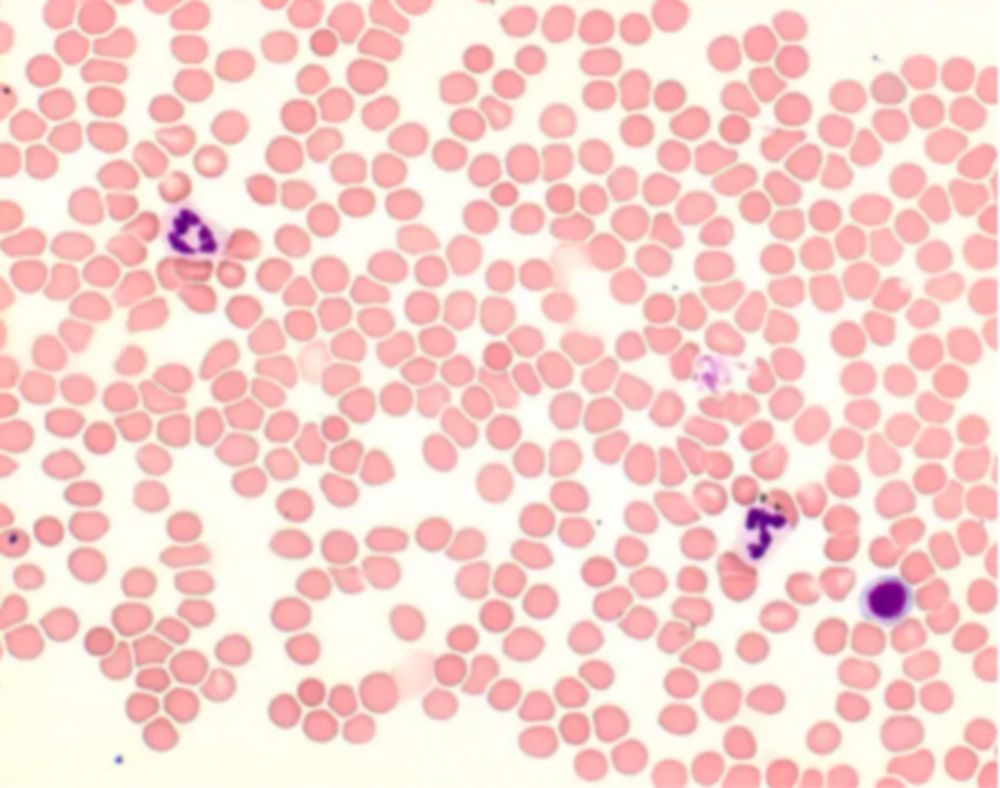
Giemsa oplossing voor  microscopie

Pipetpunten 1-5 ml, epT.I.P.S., Racks, Biopur, 120 mm, Paars, Steriel
€ 62,70
Op voorraad
Meer over: Pipetpunten 1-5 ml, epT.I.P.S., Racks, Biopur, 120 mm, Paars, Steriel
- controle op elke charge
- chargecertificaat op aanvraag
- elke doos afzonderlijk verpakt, verpakking à 5 dozen
Dezepipetpunten zijn algemene labproducten voor onderzoeksdoeleinden.
| Extra toelichting: | (5 rekjes × 24 tips) |
|---|---|
| Kleur: | paars |
| Korte omschrijving: | epT.I.P.S.® Rekjes Biopur® 0,1-5 ml, 120 mm, |
| Lengte: | 120 mm |
| Merknaam: | Eppendorf |
| Steriel: | ja |
| Toelichting: | paarse, kleurloze tips, verpakking van 120 tips |
| Type product: | Consumables |
| UNSPSC Code: | 41121600 |
| Verpakkingsvorm: | 5 x rek à 24 |
| Volume: | 100 ... 5.000 µl |
| Veiligheidsinformatieblad: | Download |
|---|
Anderen bekeken ook
Op voorraad

Op voorraad
Precisie in elk detail: De garantie voor uitstekende kwaliteit.van hoogwaardig polypropyleendichtzittend door nauwkeurig passende conusoptimale omgang door de onberispelijke vormgegarandeerd stofvrij door speciale ionisatieuitstekende transparantie door de hoge oppervlaktekwaliteitminimale vloeistofretentie door de gecontroleerde grondstofkwaliteithoge inhoudsnauwkeurigheid door nauwkeurige puntopeningpraktijkgerichte tipvoluminaniet-sterielautoclaveerbaarA: alle gangbare pipetten, ratiopetta®B: Gilson PIPETMAN® ClassicC: Gilson PIPETMAN® UltraD: Gilson PIPETMAN® NeoE: Thermo-Scientific Finnpipette® F1 / F2F: BioHit® ProlineG: BioHit® MlineH: Brand Transferpette® SI: Brand Transferpette® electronicJ: Eppendorf Reference®K: Eppendorf Reference® 2L: Eppendorf Research®M: Eppendorf Research® plusN: Socorex Acura® manual 825O: Socorex Acura® manual 835P: Socorex Acura® manual XSQ: Socorex Calibra® digital 822R: Socorex Calibra® digital 832S: Dr. Lange®T: Oxford®

Op voorraad
praktisch navulsysteem voor de epT.I.P.S. Boxtrays afhankelijk van de tipgrootte dubbelzijdig of gestapeld verpaktcontaminatievrije transfer van de trays in de werkdoostrays ook autoclaveerbaar leverbaarkleurgecodeerde trays voor eenvoudige identificatie van de puntenDeze pipetpunten zijn algemene labproducten voor onderzoeksdoeleinden.

Op voorraad
Originele pipetpunten van hoge kwaliteit tegen een attractieve prijsverpakt in hersluitbare zakkenverkrijgbaar in alle tipmaten van 10 µl tot 10.000 µl

Levertijd: 6 weken of meer
met deze Multirackswordt piepetteren nogefficiënter qua tijd, hygiënischeren praktischerde tips zitten in een stevige matrix, in 8 x 12 formaat voor alle tipversies tot 300 µlen in6 x 10 formaatvoor 200tot 1000 µlde tipopname met1-, 8- of 12-kanaalspipetten en pipetteerrobots geschiedt zonder handcontact en dus contaminatievrijde rekken zijnrobuust en stabiel,en het klapdeksel is tot 180° te openenna het werk sluit het rek de pipetpunten weer stofdicht af met een veilige kliksluitingde rekken zijn volledig autoclaveerbaar bij121°C, 20 minMultiracks zijn er in steriele en niet-steriele uitvoeringA: alle gangbare pipetten, ratiopetta®B: Gilson PIPETMAN® ClassicC: Gilson PIPETMAN® UltraD: Gilson PIPETMAN® NeoE: Thermo-Scientific Finnpipette® F1 / F2F: BioHit® ProlineG: BioHit® MlineH: Brand Transferpette® SI: Brand Transferpette® electronicJ: Eppendorf Reference®K: Eppendorf Reference® 2L: Eppendorf Research®M: Eppendorf Research® plusN: Socorex Acura® manual 825O: Socorex Acura® manual 835P: Socorex Acura® manual XSQ: Socorex Calibra® digital 822R: Socorex Calibra® digital 832S: Dr. Lange®T: Oxford®
Anderen kochten ook

Op voorraad

Levertijd: 6 werkdagen
Neodisher LaboClean FM, alkalische intensieve reiniger, vloeibaar concentraatBelangrijkste toepassingsgebiedenMechanische reiniging van laboratoriumglaswerk in laboratoria van de cosmetische, farmaceutische, minerale oliën en andere andere industrieën.EigenschappenSterke emulgerende en dispergerende werking, hoge vuilopnamecapaciteit vuilopnemend vermogen, vrij van fosfaten en oxiderende middelen, bruikbaar bij alle waterhardheden.VervuilingOliën, vetten, harsen, paraffines, organische kleurstoffen.MaterialenGlas, keramiek, roestvrij staal, kunststoffen in beperkte mate.
Op voorraad
Levertijd: 10 werkdagen
Neodisher® Z Zuur neutralisatie- en reinigingsmiddel, vloeibaar concentraat.Belangrijkste toepassingsgebiedenNeutralisatie van alkaliresten en zure voorreiniging bij de mechanische reiniging van laboratoriumglaswerk in biologische, microbiologische en chemische laboratoria, in waterlaboratoria en in laboratoria in de fosfaat-, levensmiddelen-, cosmetica-, farmaceutische- en andere industrieën.EigenschappenBijzonder materiaalvriendelijk, geschikt voor gevoelige materialen, vooral voor laboratoria die gevoelige analyses uitvoeren waarbij sporen van fosfaten en oppervlakteactieve stoffen zouden interfereren, vrij van oppervlakteactieve stoffen, fosfaten en stikstofhoudende verbindingen, op basis van organische zuren.VervuilingNeutraliseert alkaliresten, verwijdert kalkaanslag en andere in zuur oplosbare resten.MaterialenGlas, roestvrij staal, kunststoffen

Op voorraad
Ook als korte pipetten (5, 10 en 25 ml) of met wijde opening (10 ml) verkrijgbaar.Alleen voor onderzoek en ontwikkeling.

